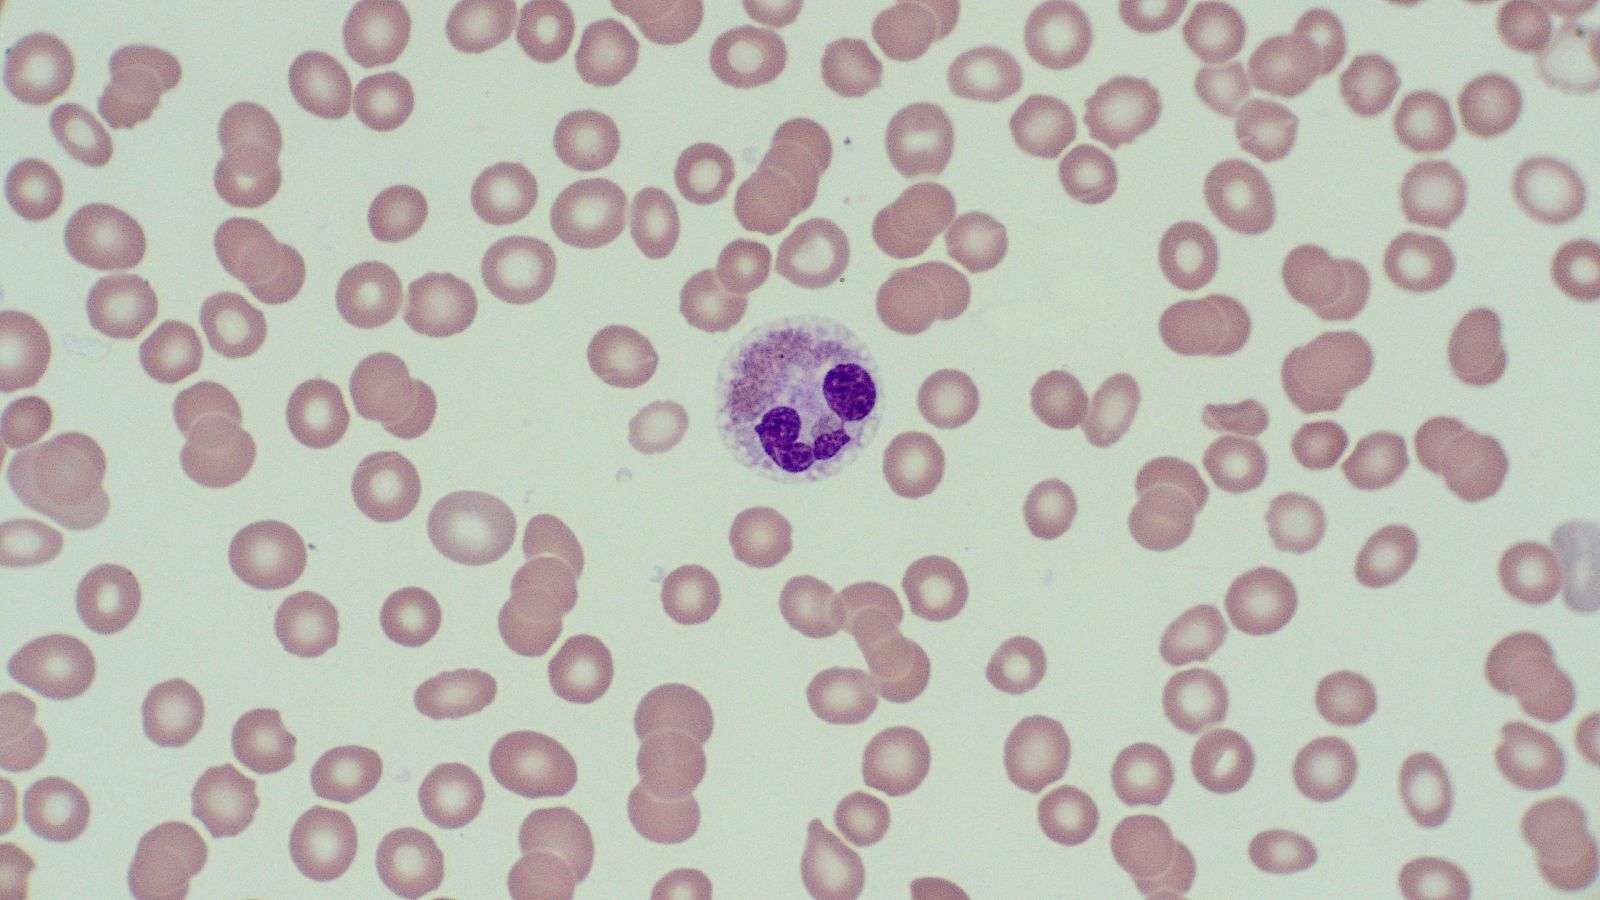
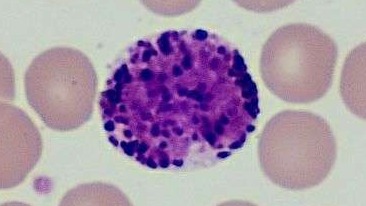

Preguntas Frecuentes
No. Está pensado para quienes ya trabajan en el laboratorio, pero aún dudan al liberar hemogramas básicos.
El paso a paso para analizar frotis con confianza, reconociendo células normales y evitando errores comunes.
Sí. El contenido es directo y práctico — diseñado para aplicación inmediata.
Sí. Tendrás acceso a un Agente Digital programado para ayudarte.
No. Es una base estratégica para fortalecer tu seguridad antes de especializaciones más profundas.
Solo nociones básicas. Si ya estudiaste o trabajas en el área, estás listo.